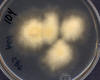
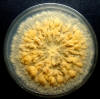
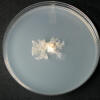
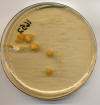
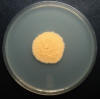
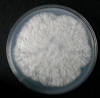
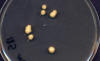
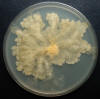
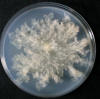
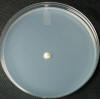
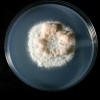
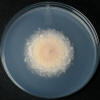
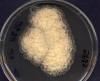

(FGSC 2489)








Pic a, Pic b, Pic c





Pic a, Pic b








Pic a, Pic b


Pic a, Pic b


| Wildtype
(74a) (FGSC 2489) |
 |
aconidiate
(acon-2) |
 |
aconidiate
(acon-3) |
 |
adherant (adh)
|
 |
| conidial
separation (csp-1) |
 |
conidial
separation (csp-2) |
 |
crosswall-less
(cwl) |
 |
fluffy
(fl) |
 |
| fluffy; dingy (fl dn) Pic a, Pic b, Pic c |
 |
 |
 |
fluffyoid (fld)
|
 |
mat
|
 |
| granular (gran) Pic a, Pic b |
 |
 |
morphological
(mo-2) |
 |
pile (pi)
|
 | |
| ragged
(rg-1) |
 |
scumbo
(sc) |
 |
skin (sk)
|
 |
frost
(fr) |
 |
| sponge (sp) Pic a, Pic b |
 |
 |
tangerine (tng) Pic a, Pic b |
 |
 |
These images were obtained using a Philips 505 scanning electron
microscope on 2% gluteraldehyde/1% paraformaldehyde fixed material treated with
OsO4 and followed by HMDS. They were air dried and sputter-coated with 20 nm
gold prior to imaging.
If you use them, you must credit Matt Springer and
the FGSC.
They should not be used for commercial purposes.
| aconidial |
 |
adherent |
 |
amycelial |
 |
bald |
 |
balloon |
 |
button |
|
| carpet |
|
coil-1 |
 |
col-1 |
 |
col-4 |
|
col-8 |
 |
col-12 |
|
| col-15 |
 |
col-16 |
 |
col-17 |
 |
col-18 |
 |
col(B235r) |
|
col(119) |
 |
| com |
|
cot-1 |
 |
crisp |
|
csh |
 |
cum |
 |
curly |
 |
| del |
 |
dingy |
 |
downy |
 |
drift |
 |
fi |
 |
fl |
 |
| frost |
 |
granular |
 |
it pokes along |
 |
mad |
 |
microcycle blastoconidiation |
|
medusa |
 |
| melon |
|
mo |
 |
patch |
 |
peak |
 |
pi |
 |
puff |
 |
| rg |
 |
rug |
|
scot |
 |
scruffy |
 |
scumbo |
 |
shallow |
 |
| shaggy |
 |
sk |
 |
smco-1 |
 |
smco-4 |
 |
smco-5 |
 |
smco-6 |
|
| smco-7 |
 |
smco-8 |
|
smco-9 |
|
snowflake |
 |
soft |
 |
spray |
 |
| spco-4 |
 |
spco-5 |
 |
spco-6 |
|
spco-7 |
 |
spco-9 |
 |
spco-10 |
 |
| spco-11 |
|
spco-12 |
 |
spg |
 |
ta |
 |
tiny |
 |
tangerine |
 |
| tenuous |
 |
velvet |
 |
visible |
|
vivid |
 |
wa |
 |
Wild-type |
 |
| Many of the images presented here were prepared by Olivera Gavric in the laboratory of Dr. AJF Griffiths | |||||||||||
| These images are available to researchers and educators for their personal
and educational use. They may be freely used in educational presentations without
restriction. They may not be repackaged, republished or incorporated in other electronic
media presentations without written permission of the FGSC. They shall not be used for
personal financial gain under any circumstances.
The images from the FGSC were generated by scanning cultures grown on Vogels minimal
at room temperature (around 22- 25 C) with variable fluorescent lighting unless indicated otherwise.
| |||||||||||